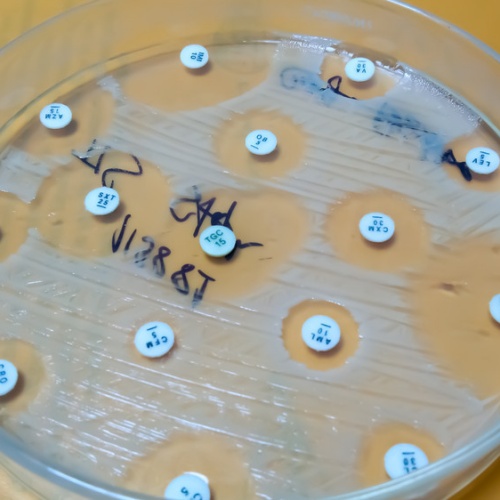

近年来,多种抗生素受到供应紧张的影响,其中之一就是万古霉素。由于特殊许可,万古霉素 CP 500 mg 可在奥地利包装下销售,期限至 4 月 30 日。
万古霉素属于糖肽类抗生素,具有明显的杀菌作用。其主要机制是抑制细菌细胞壁的合成,同时可影响细菌细胞膜的通透性以及 RNA 的合成,从而对多种革兰阳性致病菌产生作用。
在我国,万古霉素因需求增加以及生产环节问题而出现供应紧张。为了确保患者能够得到及时治疗,暂时允许使用奥地利包装的万古霉素——包括药品标签和说明书——销售,直至 4 月 30 日。随后,预计常规德国包装的药品供应将恢复。
根据德国联邦药品与医疗器械研究所(BfArM)的信息,目前万古霉素制剂(粉末,用于配制输液或口服溶液)的持续、按需供应尚不能完全保证。
万古霉素 CP 500 mg 的适应症
静脉注射(适用于所有年龄段),
复杂性皮肤及软组织感染(cSSTI),
骨与关节感染,
社区获得性肺炎(CAP),
医院获得性肺炎(HAP),包括呼吸机相关性肺炎(VAP);
感染性心内膜炎。
此外,万古霉素在所有年龄段的患者中,还可用于高风险患者在大型手术期间的围手术期抗菌预防,以降低细菌性心内膜炎发生的风险。
口服用药
万古霉素可用于治疗所有年龄段患者的 艰难梭状芽胞杆菌感染(Clostridium difficile 感染,GDI)。